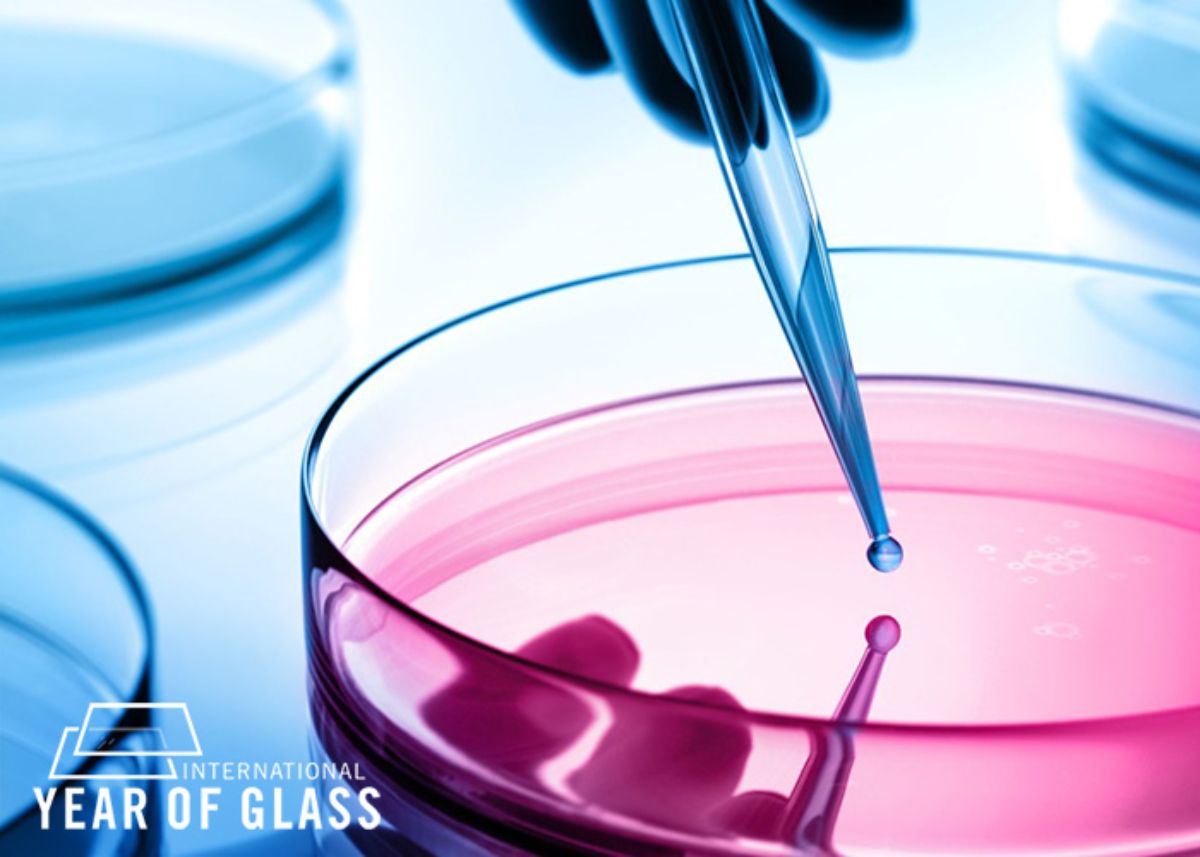
Rosa leuchtendes Glas im Vordergrund

Mit Quarzglas & mehr in eine nachhaltige Zukunft
Glas begleitet uns schon sehr lange. Die Menschheit brennt schon seit unglaublichen 9.000 Jahren Sand zu diesem transparenten und flexiblen Werkstoff. Aber erst durch die rasante Entwicklung der Werkstoffindustrie in den vergangenen 100 Jahren ist Glas wirklich in alle Lebensbereiche vorgedrungen. Als Quarzglas bietet es außergewöhnliche Einsatzmöglichkeiten in Industrie und Forschung, zum Beispiel in den Bereichen Kommunikation, Medizin, IT, Umwelt oder Weltraum. So hat es den Weg für viele Hightech-Anwendungen geebnet. Genauso vielseitig sind metallische Gläser, wie amorphe Metalle auch genannt werden. Auch hier entwickelt Heraeus Produkte und Lösungen, deren Anwendungen bis hin zu speziellen Verfahrensweisen und Stoffen für die Glasherstellung in anderen Industrien reichen. Alle wollen wir hier kurz vorstellen.

Quarzglas-Lösungen von der Erde bis zu den Sternen
Quarzglas zeichnet sich unter anderem durch seine hohe chemische Reinheit, Temperaturbeständigkeit und Lichtdurchlässigkeit vom ultravioletten bis zum infraroten Bereich aus. Die beiden Geschäftseinheiten Heraeus Conamic und Heraeus Comvance produzieren den Werkstoff. Während natürliches Quarzglas auch heute noch ganz einfach durch Einschmelzen von Sand entsteht, wird die synthetische Form durch das Verbrennen und Abscheiden eines Kondensats aus einem gasförmigen Zwischenprodukt hergestellt. Das ermöglicht die besonders hohe Reinheit.
Heraeus Comvance ist dabei der Spezialist für schnelles Internet. Seine Quarzglas-Zylinder sind die Basis für den Glasfaserausbau des globalen Datennetzwerks. Kleine Schnitte, kurze Operationszeiten und schnelle Genesung sind die Vorteile der minimal-invasiven Laserchirurgie. Heraeus Conamic liefert das Rohmaterial für die passenden synthetischen Quarzglasfasern , um den Laser in den Körper zu führen. Das Unternehmen sorgt auch dafür, dass Halbleiter für die heute so wichtigen Mikrochips richtig funktionieren. Prozessrohre aus Quarzglas stellen sicher, dass der kritische Beschichtungsprozess bei den Halbleitern optimal verläuft.

Ein weiteres nicht erst seit Corona wichtiges Feld ist die UV-Desinfektion von Wasser oder Luft. Quarzglas für hochreine Lampenrohre von Heraeus Conamic ermöglicht UV-Lösungen des Geschäftsbereichs Heraeus Noblelight das sichere Abtöten von Bakterien oder Viren. Hoch hinaus geht es bei Quarzglas für die Weltraumerforschung. Auf dem Mond steht beispielsweise seit der Apollo 11-Mission von 1969 ein Laserreflektor mit 100 Quarzglas-Prismen, mit dessen Hilfe sich bis heute zuverlässig die Entfernung zwischen Erde und Mond messen lässt.
Metallische Gläser mit eiskalten Vorteilen
Schockfrosten kann erstaunliche Ergebnisse zeigen. Aus metallischen Schmelzen entstehen metallische Gläser , die auch als amorphe Metalle oder Legierungen bezeichnet werden. Das Resultat sind Werkstoffeigenschaften, die sich normalerweise gegenseitig ausschließen wie hohe Festigkeit bei gleichzeitig hoher Elastizität. Das macht solche Gläser zum begehrten Material für viele Industrien wie Medizintechnik, Automotive, Robotik, Sensorik oder die Luft- und Raumfahrt.

Quarzglas macht schöner und sicherer
UV-Lampen und -Systeme oder Infrarotstrahler von Heraeus Noblelight mit Quarzglas-Komponenten von Heraeus Conamic sind bei der Glasverarbeitung in vielen Industrien im Einsatz. Auf diese Weise erhalten Parfümflakons durch Dekors und Beschichtungen ihren anziehenden Look. Infrarot-Strahler helfen, die Dichtungen von Autoscheiben sicher zu verkleben und passen sich dabei perfekt den Fertigungszyklen an. Zudem hat Infrarottechnologie vor einigen Jahren auch in der Medizintechnik Einzug gehalten. Hier zahlt sich besonders aus, dass sie auch in Reinräumen und unter Vakuum einsetzbar sind. So lassen sich beispielsweise Glasampullen für Impfstoffe keimfrei bruchsicher machen.

Edelmetall glänzt bei der Glasproduktion
Was wäre unser Alltag ohne modernes Glas? Unvorstellbar. Glas ist unser täglicher Begleiter und bereichert unser Leben - ob als Coverglas auf dem Smartphone-Display, als Linse in einer Kamera oder als Verpackung für Impfstoffe. Hochwertige technische und medizinische Gläser benötigen bei ihrer Herstellung Edelmetalle wie Platin und Rhodium. Mit diesen Edelmetallen und deren Legierungen lassen sich innovative, anspruchsvolle Glasarten verarbeiten und sie behalten ihre charakteristischen Eigenschaften – etwa höchste Flexibilität für faltbare Displays oder Bruchsicherheit als Glasampulle. Ohne Edelmetalle mit ihrer Langlebigkeit und ihrem hohen Schmelzpunkt ist die Verarbeitung und Herstellung solch hochmoderner Gläser unmöglich. Die Spezialisten der Geschäftseinheit Heraeus Precious Metals bieten die passenden Produkte und Services rund um alle relevanten Edelmetalle zur Glasherstellung.